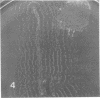

Abstract
Micrococcus luteus cells died relatively rapidly when they were added to natural soil. Microscopic observation showed that the cells were being physically destroyed by bacterial predators in the soil. Two of these predators were responsible for the initial, main attack, and they were isolated. The isolates on laboratory media lysed M. luteus cells in a manner similar to the attacks that occurred in soil. Neither predator was obligate, however, nor were they nutritionally fastidious. One of these bacteria produced mycelium and conidia. Under nutritionally poor conditions it used slender filaments of mycelium to seek out host cells. It had at least some of the characteristics of a Streptoverticillium species. The other bacterium was a short, gram-negative rod that did not easily fit into any of the known groups of gram-negative bacteria. It attached to host cells, but its mechanism of lysing these cells is not known.
Full text
PDF






Images in this article
Selected References
These references are in PubMed. This may not be the complete list of references from this article.
- Balkwill D. L., Casida L. E. Attachment to autoclaved soil of bacterial cells from pure cultures of soil isolates. Appl Environ Microbiol. 1979 May;37(5):1031–1037. doi: 10.1128/aem.37.5.1031-1037.1979. [DOI] [PMC free article] [PubMed] [Google Scholar]
- Balkwill D. L., Rucinsky T. E., Casida L. E., Jr Release of microorganisms from soil with respect to transmission electron microscopy viewing and plate counts. Antonie Van Leeuwenhoek. 1977;43(1):73–87. doi: 10.1007/BF02316212. [DOI] [PubMed] [Google Scholar]
- Casida L. E. Death of Micrococcus luteus in Soil. Appl Environ Microbiol. 1980 May;39(5):1031–1034. doi: 10.1128/aem.39.5.1031-1034.1980. [DOI] [PMC free article] [PubMed] [Google Scholar]
- Casida L. E., Jr, Liu K. C. Minute tubular forms in soil. Can J Microbiol. 1979 Jun;25(6):722–729. doi: 10.1139/m79-105. [DOI] [PubMed] [Google Scholar]
- Casida L. E., Jr Observation of microorganisms in soil and other natural habitats. Appl Microbiol. 1969 Dec;18(6):1065–1071. doi: 10.1128/am.18.6.1065-1071.1969. [DOI] [PMC free article] [PubMed] [Google Scholar]
- Casida L. E., Liu K. C. Arthrobacter globiformis and Its Bacteriophage in Soil. Appl Microbiol. 1974 Dec;28(6):951–959. doi: 10.1128/am.28.6.951-959.1974. [DOI] [PMC free article] [PubMed] [Google Scholar]
- Habte M., Alexander M. Further evidence for the regulation of bacterial populations in soil by protozoa. Arch Microbiol. 1977 Jun 20;113(3):181–183. doi: 10.1007/BF00492022. [DOI] [PubMed] [Google Scholar]